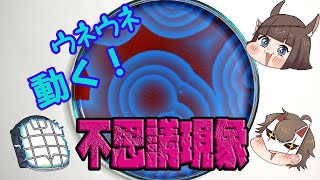

【ガチ実験シリーズ】熱湯で金属が溶ける! 低融点合金を自作する
概要
動画投稿日|2022年3月20日
動画の長さ|10:46
《高評価、チャンネル登録をぜひよろしくお願いします!!》
▷薬理凶室メンバーTwitter
くられ:https://twitter.com/reraku
ツナっち:https://twitter.com/t_naoya_807
亜留間次郎:https://twitter.com/aruma_zirou
淡島りりか:https://twitter.com/148553_50_8
しろへび:https://twitter.com/shirohebiyakuri
Joker:https://twitter.com/JokerLunatic
レイユール:https://twitter.com/rayure_chemist
デゴチ:https://twitter.com/degochiyakuri
yasu(ヤス):https://twitter.com/Shyasuna
▷出演・声優・イラストTwitter
うるちまい子:https://twitter.com/urutimaiko
かふん:https://twitter.com/kafun
くがほたる:https://twitter.com/H3r4x
夢路キリコ:https://twitter.com/yumejikiriko
八幡ケイ:https://twitter.com/Cei_YhT
元素:https://twitter.com/porogenso
▷動画シリーズ一気見はコチラ!
【続 科学は全てを解決する!】
https://www.youtube.com/playlist?list=PLqb1_bSznVpmVz-rvMAWZWpfDowe8r6co
【薬理凶室シリーズ】
https://www.youtube.com/playlist?list=PLqb1_bSznVpnHhrb1nSDVqIDIaNkh6YbO
【教科書さんシリーズ】
https://www.youtube.com/playlist?list=PLqb1_bSznVpkeQ_pRLjRyFkBEBzYL-54e
【毒物ずかん/ドヤれる科学】
https://www.youtube.com/playlist?list=PLqb1_bSznVplb0x1mVlPJSl1iKXR99hXv
【そのほかのコラボ動画など】
https://www.youtube.com/playlist?list=PLqb1_bSznVpk4-K60YDNRM9pxN9ReO4fc
▷アリエナイ理科の最新刊
購入はコチラから↓
https://www.sansaibooks.co.jp/arienai
▷アリエナイ理科ポータル
科学記事・グッズ・仕事のご相談はこちらから↓
https://www.cl20.jp/portal/cosmetic_lyrica/
お悩み相談はこちらから↓
https://www.cl20.jp/portal/movie-question-box/
●LIVE放送の切り抜きなどについて
現在、外部の方による切り抜き動画に作成に関してはお断りしております
▷BGM・音楽素材
DOVA-SYNDROME
http://dova-s.jp/
効果音ラボ
http://soundeffect-lab.info/
関連動画

12:38
色が次々変わる超映え実験 実は誰でもできるんです! 【ガチ実験シリーズ】科学はすべてを解決する! [くられ with 薬理凶室]

11:35
水一滴で即発火 超危険反応で火をつけろ!?【ガチ実験シリーズ】科学はすべてを解決する! [くられ with 薬理凶室]
12:03
超ふしぎ! 動く模様を生み出す【ガチ実験シリーズ】科学はすべてを解決する! [くられ with 薬理凶室]

11:17
ただの炎色反応じゃない!? 緑の燃焼ガスで緑のライターを作る科学はすべてを解決する! [くられ with 薬理凶室]

10:19
麻酔薬製造 キシロカインを合成する【ガチ実験シリーズ】科学はすべてを解決する! [くられ with 薬理凶室]
関連用語